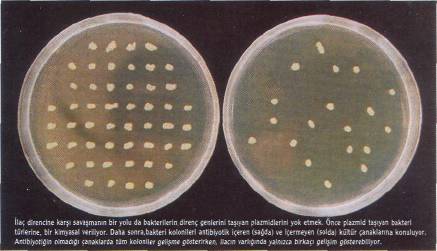
b-5.jpg

|
|
|
gellemede önemli bir önlem. Daha önceden olduğumuz aşıların geçerliliğini koruyup korumadığını soruşturmakta, özellikle grip ve zatürree aşılarını yaptırmakta yarar var. Sebze ve meyveleri iyi yıkamak, çiğ yumurta, az pişmiş et ve özellikle kıymadan kaçınmak ve gıdaları uygun ısılarda saklamak gerekiyor. Çünkü kesim ve paketleme işlemleri sırasında hayvanların üzerinde kalan bakteriler, mutfaklarımızın yolunu tutuve-riyor. Pişirme işlemi çoğunu öldürse de, az pişirilmiş etler hâlâ bakterilere ev sahipliği yapıyor. Ayrıca çiğ et, tavuk ve balıkla temas eden diğer gıdalar da bakterilerden nasibini alıyor. Çoğu kimse, bu bakterilerden dolayı hafif ve orta şiddetli rahatsızlıklara yakalanıyor. Ancak, hastalanan insanlara, hayvanlarda kullanılana benzer ilaçlarla tedavi uygulanacağından ve dirençli bakteri bu kişiye zaten geçmiş olduğundan, ilaç etkili olamıyor.
Doktorlar, yazdıkları antibiyotik reçetelerini kısıtlayabilirler. Mümkün olduğu kadar dar spektrumlu antibiyotikleri önerebilir, geniş spektrumlu ilaçları, eski ilaçlara direnç gösteren enfeksiyonlara saklayabilirler. Her hasta muayenesinden sonra ellerini yıkayabilirler. Hastaları antibiyotik direnci riski konusunda bilgilendirebilirler. Hastaların gerekli aşıları yaptırmalarını sağlayabilirler. Her durumda ya-pılamasa da kültür ve etkinlik testleriyle, enfeksiyonun bakteri kaynaklı olduğunu kesinleştire-rek reçete verebilirler.
Hastanelerse, hastane personelinin daha sık ve uygun şekilde ellerini yıkamasında ısrarcı davranabilir, buraları sağlığa daha uygun bir duruma getirmek için çalışabilir, dirençli enfeksiyon taşıyan hastaları daha çabuk belirleyerek, diğer hastalardan ayırabilirler.
mantığının nasıl bir şey olduğunu gayet iyi biliyoruz; ama elimizde onları uysallaştırmak için kullanabileceğimiz moleküler mekanizmalara ait bilgiler de var. Hastaların, doktorların, araştırmacıların, ilaç şirketlerinin, tarım ve hayvancılık sektörünün ve bizlerin, elimizdeki silahların değerini bilememiş olmaktan ders almamız ve bakterilerin bir kez daha kitleleri öldürür hale gelmesini önlemek için hep birlikte çalışmamız gerekiyor. Maçın ilk yarısında karşı takıma ezildik. Umalım ki, ikinci yarıda atacağımız goller maçı kazanmamızı sağlasın.
Meltem Y. Coşkun
Kaynaklar:
Amâbile-Cuevas,C,F., "New Antibiotics and New Resistance", American Scientist, Mart Nisan 2003
lıttp://www. fda.gov
http ://www. cspinet.org/ar/
|
|
|
|
|
|
Toplum sağlığı açısından bakıldığında, antibiyotiklerin gereksiz kullanımı oldukça tehlikeli ve bir o kadar da maliyetli. Oysa, çok az yan etkileri olduğundan, çoğu antibiyotiğe, yararı do-kunmasa bile zararı olmayacak ilaçlar gözüyle bakılıyor ve tereddüt etmeden bolca kullanılıyor. Örneğin sık seyahat edenlere ishal önleyici antibiyotikler yazılıyor. Pek çok hastanenin acil servisinde, daha bir enfeksiyonun varlığı bile belirlenmeden antibiyotik uygulanıyor. Bu tür uygulamaların kişiye yararı olmasa bile, dirençli bakterilerin yararına olduğu kesin.
Bakterilerle savaşta o kadar katıyız ki, bize sıkıntı veren bu organizmları tümüyle yok etmek için antibiyotiklere yüklenip duruyoruz. Tıpkı pek çok temizlik ürününe dezenfektan katma çabamızda olduğu gibi. Oysa bazı sağlık uzmanlarına göre antibakteriyel sabunların ya da deterjanların kullanımının toplum sağlığına yararlı olduğu yönünde bir kanıt bulunmuyor. Bu uzmanlar, iyi bir sabun ve suyun pek çok durumda yeterli olacağı, antibakteriyel ürünlerin hastane ortamlarına, hastaneden yeni çıkmış hastalara ve bağışıklık sistemi tehlikede olanlara saklanması gerektiğini düşünüyorlar.
Gerekli durumlarda antibiyotik kullanırken de uymamız gereken kurallar var.
İlacı aldığımız süre boyunca kendimizi iyi hissetmeye başlasak bile, önerilen zamandan önce ilaç alımını bırakmamalı ve belirlenen saatlerde almaya özen göstermeliyiz. Aksi halde, tedavinin etkinliğini azaltmış, bakterinin de direnç geliştirme olasılığını artırmış oluruz. Ayrıca, gelecekte bu ve diğer ilaçların tedaviye yanıt vermesini de engelleriz. Çünkü, dozu tamamlanmamış antibiyotikler, bakterilerin canlı kalmasına ve enfeksiyonun tekrarlamasına neden olur. Üs-
kete geçmiş bir hastalık yapıcıdan kurtulmak için yeterli değil. Öldürücü olmayan bu ilaçların etkinliklerini denemek bile, bakterilerin büyüyüp büyümediğini kolayca izlemek mümkün olmayacağından, tümüyle yeni teknolojiler gerektirecek. Ayrıca, zehir baskılayıcıların yalnızca birkaç organizmayı etkileyecek dar bir spektrumu olacağından, genelde iki üç gün alan enfeksiyon türünü belirleme yöntemlerinin da geliştirilmesi gerekecek.
Direnç savaşında, dirençli genleri taşıyan plazmidler de hedef olarak belirleniyor. Bu konuda, tıp dünyasına yeniden dönüş yapan bakteriyofajların (bakterilere saldıran virüsler) önemli katkısı olacak gibi. Bilimadamları, as-korbik asitin (C Vitamini) bakteriyofajların kopyalanmasını durdurduğunu gösteren eski çalışmalara dayanarak ve bakteriyofajlarla plazmidlerin DNA' larının birbirine çok benzediğini
|
|
telik canlı kalan bakteriler en dayanıklılarıdır. Yani, ikinci enfeksiyon, ilkinden daha şiddetli geçer. Ayrıca oluşan dirençli bakteri, hastanın ait olduğu topluluğa da geçebilir. Bu durumda en fazla risk taşıyanlar hastane çalışanları, evlerde hastabakıcılık yapanlar ve insanların sık sık hastalandığı ortamlarda bulunanlar. Bu insanların vücudunda dirençli mikropların oluşması olasılığı oldukça fazla.
Daha çabuk iyileştireceği düşüncesiyle doktorlardan ısrarla antibiyotik istenmesinin anlamsızlığına birkaç örnek verelim: Boğaz ağrılarının çoğu virüs kaynaklıdır. Yalnızca yaklaşık %15'i Streptococcus kaynaklıdır. Boğaz kültürüyle, rahatsızlığın bakteri kaynaklı olup olmadığı ve hangi antibiyotiğin işe yarayacağı belirlenebilir. Öksürük ve bronşit de çoğu zaman virüs kaynaklıdır. Çocuklarda sıkça rastlanan kulak enfeksiyonlarının da antibiyotik gerektirmeyen pek çok çeşidi vardır. Çocuklar soğuk aldığında, kulakta su birikir ve bu genelde hiçbir tedaviye gerek kalmadan kendiliğinden kaybolur. Genelde ateş, iştahsızlık, tedirgin uyku, ağrı gibi belirtilerle birlikte gelişmediği sürece, antibiyotiğe gereksinim duyulmaz. Ancak, viral gibi başlayanlar bir-kaç gün sonra bakteriyel enfeksiyonlara da dönüşebilir. Sinüs enfeksiyonları da virüslerden kaynaklanabilir. Sarımsı ya da yeşilimsi burun akıntısı da, her zaman için bakteriyel bir enfeksiyonun habercisi değildir.
Antibiyotikleri düzenli ve gerekli yerlerde kullanmaktan başka yapabileceğimiz şeyler de var. Örneğin, eski reçetelerden kalma antibiyotikleri başka hastalıklarda kullanmamak ve bunları tanıdıklarla paylaşmamak gerekiyor. Ellerimizi sık ve iyice yıkamak, elbette taşıdığımız dirençli bakterilerin başkalarına bulaşmasını en-
göz önüne alarak, askorbik asitin anti-plazmid faaliyetlerini incelemişler ve oldukça iyi sonuçlar almışlar. Benzer faaliyetlerde bulunabilecek bileşikleri araştırdıklarındaysa, ilginç ilaç adaylarına ulaşmışlar. Bu yaklaşım belki yalnızca birkaç plazmid-bakteri bileşiminde yararlı olabilecek; ancak, dar spekt-rumlu ilaçlar bile tehlikedeki hastalan tedavi ederken çok değer kazanıyor. Ayrıca, bazı zehir belirleyici etkenler, özellikle plazmidlere bağlı. Bunların kararlılığını bozmak yararlı olabilir. Örneğin, antraks'a neden olan Bacillus anthratis'le, neredeyse tümüyle zararsız toprak bakterisi Bacillus cere-us arasındaki ana fark, zehirli bir plaz-mid. Bu plazmid, araştırmalar için sı-radışı bir hedef olabilir.
Bakterilere karşı verilen savaşta, antibiyotiklerin ilk keşfedildikleri yıllarda sanılanın tersine, ağır bir yara aldık. Artık, dayanıklı bakterilerin düş-
|
|
|